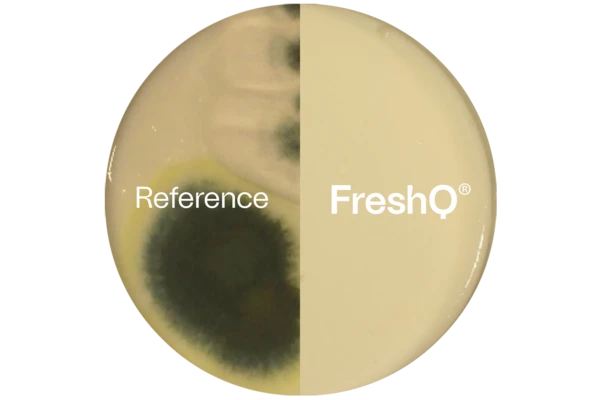
Two images of a petri dish spliced into one. On the left is the reference, with heavy mold growth. On the right is FreshQ, which is mold-free.

Get next-level consistency in fermented milk
Consistency helps you get more from your inputs while delivering the next-level quality consumers love. We can help you take your consistency to the next level.
Achieve consistent quality throughout your process
Get consistent fermentation and low post-acidification in dairy with our starter cultures. Achieve consistent dosing with Novonesis’ one-bag Direct Vat Set (DVS®) solutions. Minimize the risk of phages and antibiotic residues impacting your product quality. And unlock quality throughout shelf life with fermentation-enabled bioprotection.

Yeast and mold contamination in your value chain
Why and where does contamination happen?
Yeast and mold are commonplace in a range of environments. So it’s no surprise that they’re the most common causes of spoilage in fermented milk products. Read on to discover where risk of contamination is highest in the dairy value chain.

At the dairy
The number of handling steps at the dairy increases contamination risk. And the risk increases further with any deviation from standard production. Less-than-optimal hygiene and product ingredients such as fruit preparations also increase the risk.

During packaging
Air is the main source of contamination during packaging. Factors influencing the level of risk include plant design, nearby industrial activity and weather conditions. Packaging materials are another potential source of contamination.

In distribution and retail
While the risk of contamination is generally low during distribution and in the supermarket, this is very much dependent on storage conditions. Temperature and storage time are both risk factors in spoilage.

In people’s homes
Once your products make their way into people’s homes, the risk of contamination rises. That’s because there are just so many potential contamination sources once the product is opened. These include the inside of the refrigerator, spoons and the air in the home.

Reduce your risk and take control with FreshQ®
If consumers have a bad experience with your product, they’re unlikely to complain. Instead they’ll simply stop buying, and probably tell their friends to do the same. That’s why spoilage is a silent brand killer.
If spoilage leads to a product being recalled, the impact on a brand can be catastrophic. Recalls damage relationships with retailers and can lead to negative media coverage.
So why not take control of yeast and mold by including Novonesis’ FreshQ® in your fermentation process?
Next-level freshness benefits with FreshQ®
We put FreshQ® to the test by fermenting two yogurt samples with a starter culture. We added FreshQ® to one sample. Then we spiked the samples with various species of mold that cause spoilage in fermented milk. The results were clear: FreshQ® delayed the growth of all species of mold.
Various penicillium species
Molds with different growth characteristics were spiked with 500 spores/spot. Evaluated after 28 days at 7°C.
Take your phage management to the next level
Bacteriophages are a key threat to consistent quality in fermented milk. Phage attacks on weakened culture systems can ruin entire product batches. And dealing with phages can lose your team hours or even days. With our products and services, you can take your phage management to the next level.

Robust cultures
Access the largest selection of cultures for fermented milk and cheeses in the world, designed to be robust against phage attacks.

Novonesis’ PhageWatchTM service
Access detailed sample analyses, phage and process reviews and intuitive digital tools. All underpinned by continuous support from our experts.

Application support
Get expert support to identify the optimal culture rotation with the best monitoring to help reduce your risk of phage attacks.
Next-level convenience and consistency with DVS®
Unlock next-level convenience with our DVS® (Direct Vat Set) cultures. Simply add them directly to your milk in the vat, with no need for prior activation.
Direct inoculation with these highly concentrated and standardized cultures also gives you greater consistency than bulk starters. That’s because strain ratios in the bulk starter tank shift over time. The result is inconsistency in the acidification slope and flavor. With DVS® cultures you get the same culture composition in each and every vat.

Biosolutions for consistent quality

- Extend shelf life
- Stay fresh
- Take control
- Go natural

- High texture achieved naturally
- Mild flavor throughout prolonged shelf life
- Increased flexibility in production

- Superior pH stability
- Cost reduction in a warm filling process
- Mild base for your product innovation
Let’s get next-level consistency together
If you’re looking for ways to boost your consistency, fill out the form below and we’ll get back to you.
One more step…
To complete the get in touch form or sign up, please click on the button below to enable cookies.